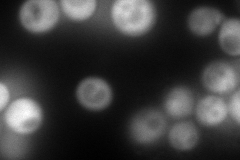
YHR025W
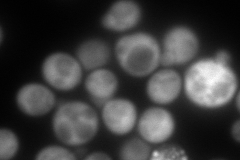
YHR025W
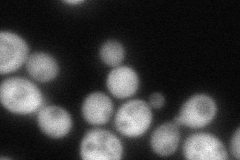
YHR025W
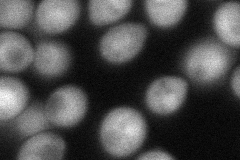
YHR025W

View description
Homoserine kinase, conserved protein required for threonine biosynthesis; expression is regulated by the GCN4-mediated general amino acid control pathway
Localization:
Intensity:
Fold change:
Significance:
-
C’ GFP library in SD

punctate79.44 -
N' NOP1pr-GFP in SD
cytosol296.979 -
N' TEF2pr-mCherry in SD
cytosol373.279 -
N' NATIVEpr-GFP in SD
cytosol95.0531 -
N' TEF2pr-VC and Cyto-VN in SD
cytosol,nucleus80.8622 -
C’ GFP library in SD+DTT

punctate79.110.99No -
C’ GFP library in SD+H2O2

punctate92.391.16No -
C’ GFP library in Starvation Media

punctate137.481.73Yes -
C’ GFP library on the background of Pup2-DaMP

punctate -
C’ GFP library on the background of CCT mutant

punctate85.03441.0704No
